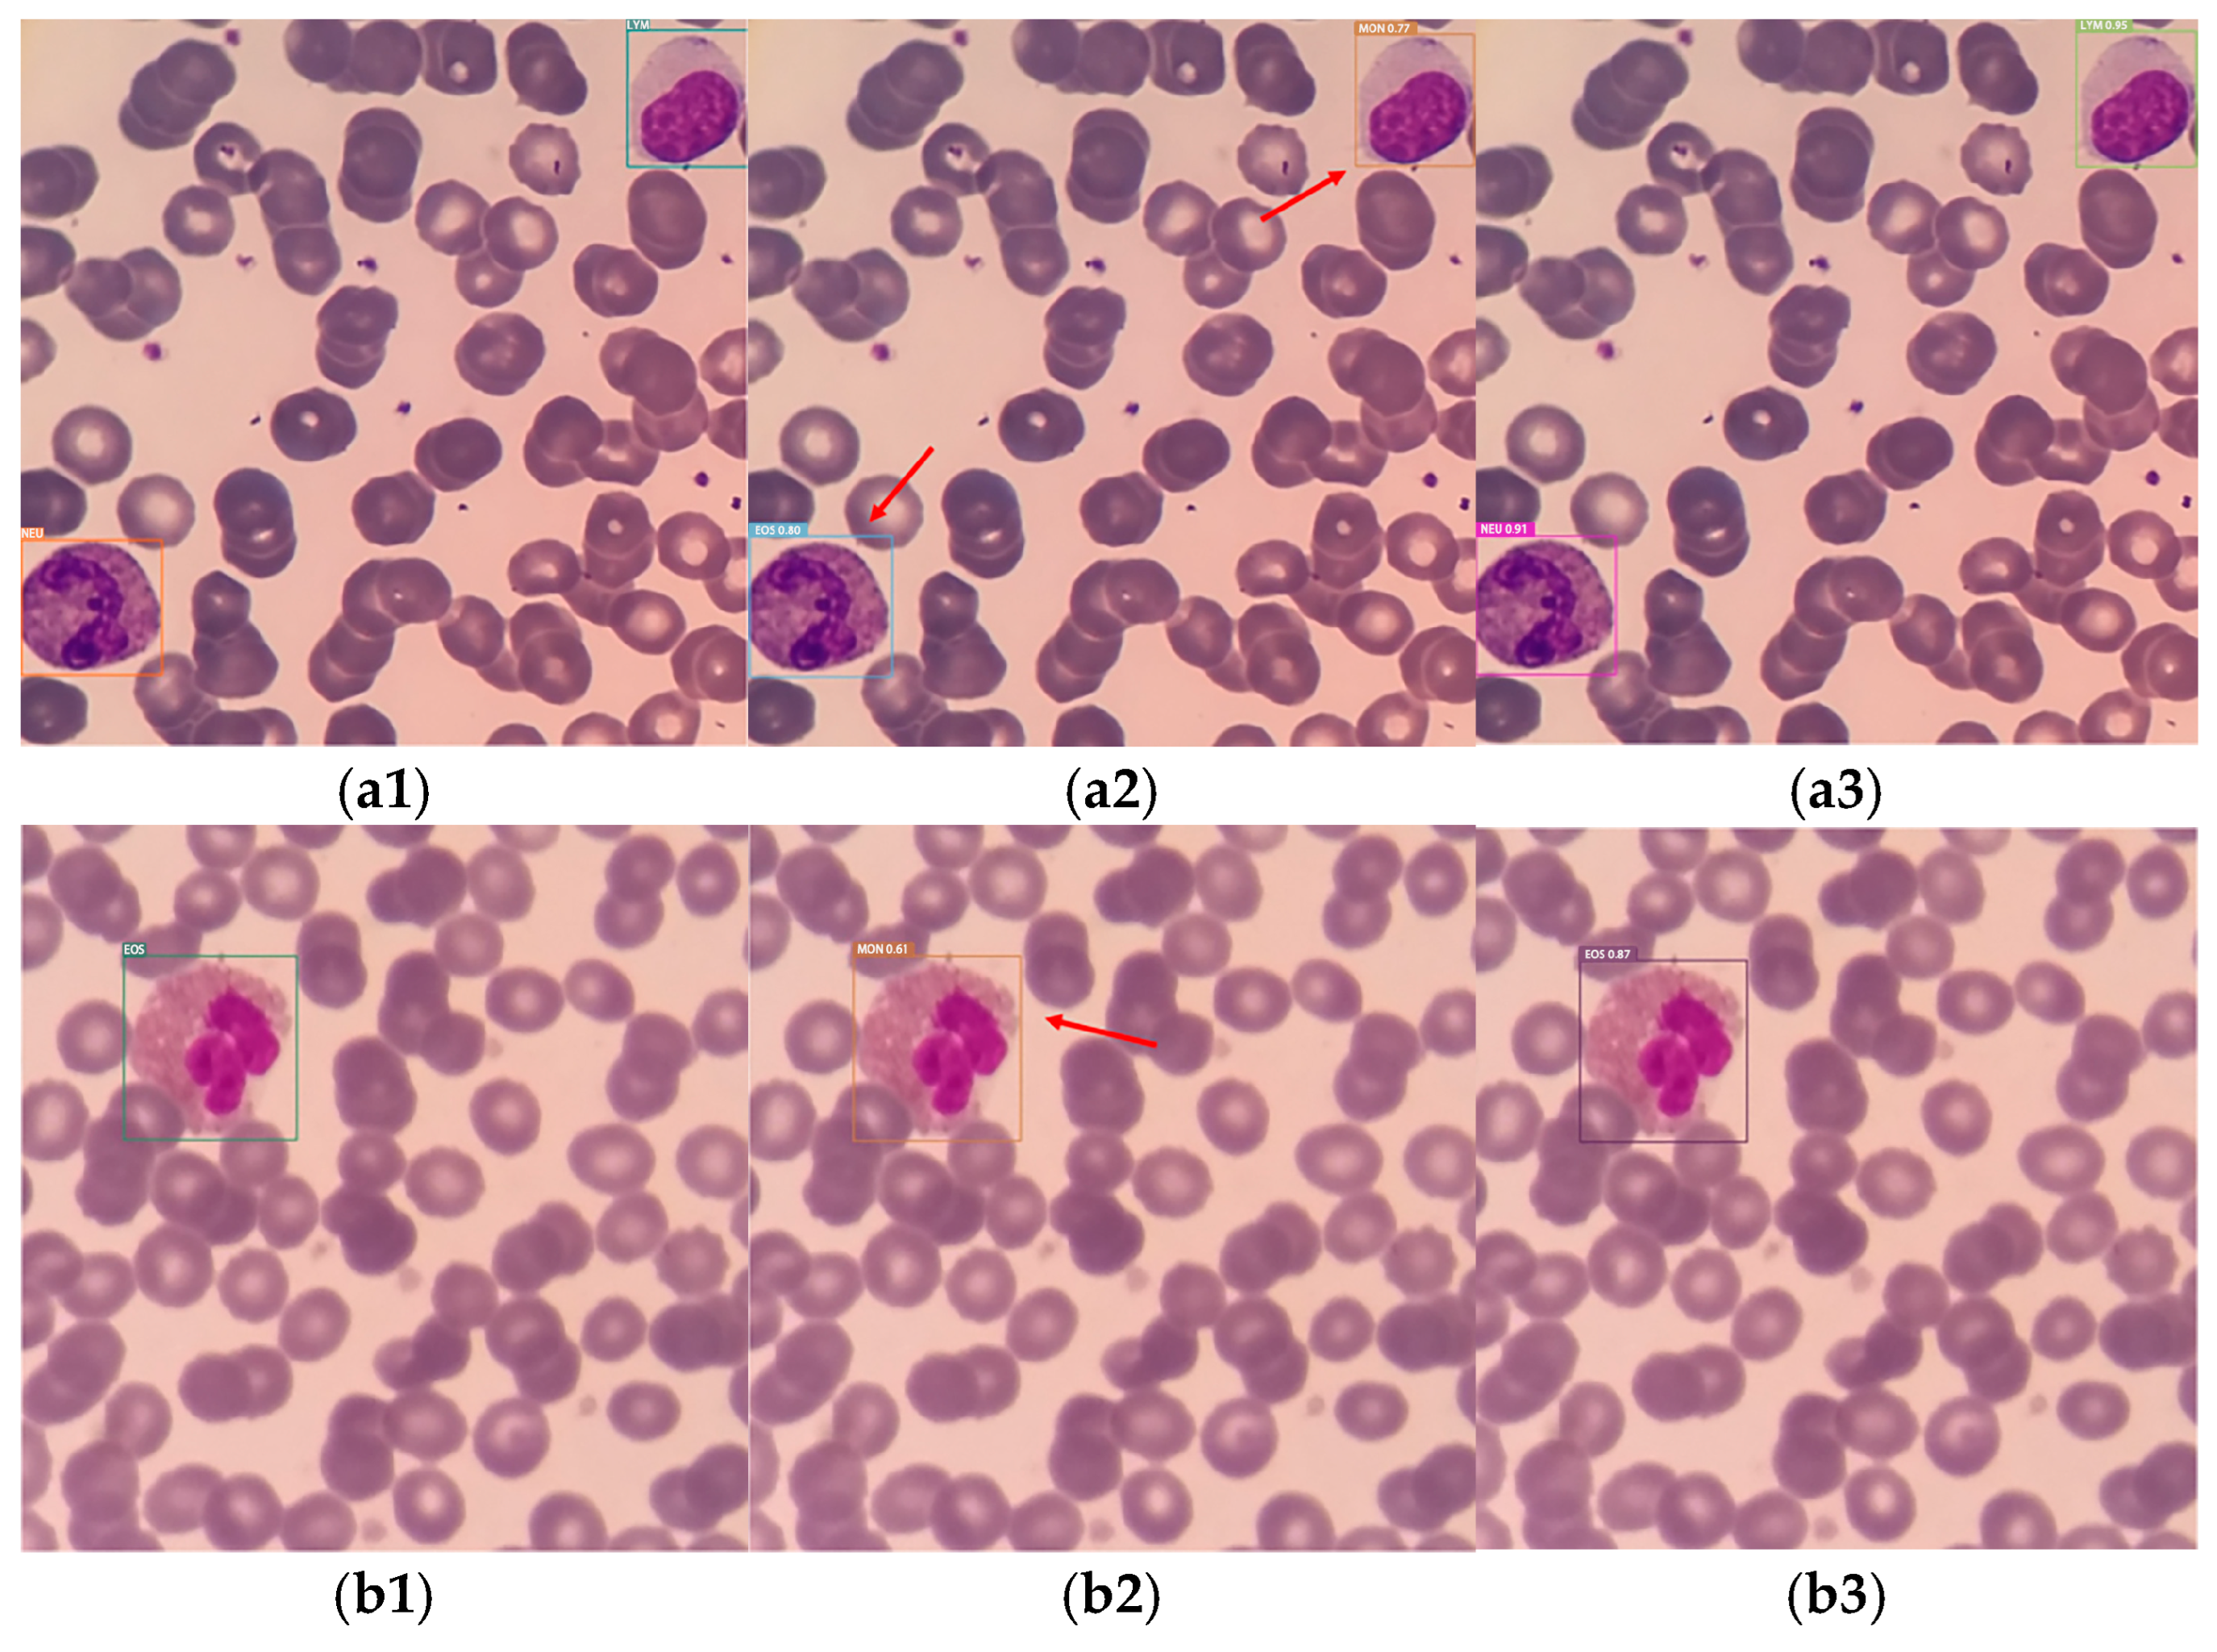
Sensors 25 02699 g010a
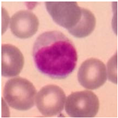
Sensors 25 02699 i002
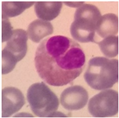
Sensors 25 02699 i003
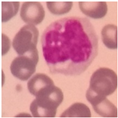
Sensors 25 02699 i004

Research and Optimization of White Blood Cell Classification Methods Based on Deep Learning and Fourier Ptychographic Microscopy
Abstract
1. Introduction
2. Related Works
2.1. Imaging Technology
2.1.1. Introduction to Fourier Microimaging
2.1.2. Leukocyte Dataset
2.2. White Blood Cell Detection
2.2.1. White Blood Cell Classification
2.2.2. Image Processing-Based Methods
2.2.3. Deep Learning-Based Approach
3. Method
3.1. CCE-YOLOv7 Network Architecture
3.1.1. Conv2Former-Based Backbone Networks
3.1.2. CARAFE Lightweight Upsampling Operator
3.1.3. Efficient Multi-Scale Attention Module
3.1.4. Non-Maximum Value Suppression Optimization
4. Experiment and Results
4.1. Experimental Environment and Configuration
4.2. Performance Evaluation Indicators
4.3. Experimental Results and Analysis
4.3.1. Analysis of the Results of the Improved Backbone Network
4.3.2. Analysis of the Results of Improve Sampling
4.3.3. Analysis of Ablation Experiment Results
4.3.4. Analysis of Comparative Experimental Results
5. Summary
Author Contributions
Funding
Institutional Review Board Statement
Informed Consent Statement
Data Availability Statement
Conflicts of Interest
References
- Chen, Y. The value of blood smear analysis in routine blood test. Chin. Med. Guidel. 2018, 16, 118–119. [Google Scholar]
- Wang, C.Y.; Bochkovskiy, A.; Liao, H.Y.M. YOLOv7: Trainable bag-of-freebies sets new state-of-the-art for real-time object detectors. In Proceedings of the IEEE/CVF Conference on Computer Vision and Pattern Recognition (CVPR), Vancouver, BC, Canada, 17–24 June 2023; pp. 7464–7475. [Google Scholar]
- Yu, W.; Liu, F.; Xia, J. Clinical comparative study between blood cell analyzer results and blood smear analysis in abnormal cases. Chin. Med. Innov. 2016, 13, 58–61. [Google Scholar]
- Zheng, G.; Horstmeyer, R.; Yang, C. Wide-field, high-resolution Fourier ptychographic microscopy. Nat. Photonics 2013, 7, 739–745. [Google Scholar] [CrossRef] [PubMed]
- Horstmeyer, R.; Ou, X.; Zheng, G.; Willems, P.; Yang, C. Digital pathology with Fourier ptychography. Comput. Med. Imaging Graph. 2015, 42, 38–43. [Google Scholar] [CrossRef] [PubMed]
- Konda, P.C.; Taylor, J.M.; Harvey, A.R. Parallelized aperture synthesis using multi-aperture Fourier ptychographic microscopy. arXiv 2018, arXiv:1806.02317. [Google Scholar]
- Song, P.; Jiang, S.; Zhang, H.; Huang, X.; Zhang, Y.; Zheng, G. Full-field Fourier ptychography (FFP): Spatially varying pupil modeling and its application for rapid field-dependent aberration metrology. APL Photonics 2019, 4, 050802. [Google Scholar] [CrossRef]
- Wei, H.; Du, J.; Liu, L.; He, Y.; Yang, Y.; Hu, S.; Tang, Y. Accurate and stable two-step LED position calibration method for Fourier ptychographic microscopy. J. Biomed. Opt. 2021, 26, 106502. [Google Scholar] [CrossRef]
- Zhu, Y.; Sun, M.; Wu, P.; Mu, Q.; Xuan, L.; Li, D.; Wang, B. Space-based correction method for LED array misalignment in Fourier ptychographic microscopy. Opt. Commun. 2022, 514, 128163. [Google Scholar] [CrossRef]
- Lee, B.; Hong, J.Y.; Yoo, D.; Cho, J.; Jeong, Y.; Moon, S.; Lee, B. Single-shot phase retrieval via Fourier ptychographic microscopy. Optica 2018, 5, 976–983. [Google Scholar] [CrossRef]
- Zhou, Y.; Wu, J.; Bian, Z.; Suo, J.; Zheng, G.; Dai, Q. Fourier ptychographic microscopy using wavelength multiplexing. J. Biomed. Opt. 2017, 22, 66006. [Google Scholar] [CrossRef]
- Sun, J.; Chen, Q.; Zhang, J.; Fan, Y.; Zuo, C. Single-shot quantitative phase microscopy based on color multiplexed Fourier ptychography. Opt. Lett. 2018, 43, 3365–3368. [Google Scholar] [CrossRef] [PubMed]
- Shu, Y.; Sun, J.; Lyu, J.; Fan, Y.; Zhou, N.; Ye, R.; Zheng, G.; Chen, Q.; Zuo, C. Adaptive optical quantitative phase imaging based on annular illumination Fourier ptychographic microscopy. PhotoniX 2022, 3, 24. [Google Scholar] [CrossRef]
- Kuang, Z.; Yu, J.; Li, Z.; Zhang, B.; Fan, J. Integrating multi-level deep learning and concept ontology for large-scale visual recognition. Pattern Recognit. 2018, 78, 198–214. [Google Scholar] [CrossRef]
- Ju, X. The value of routine blood tests in infection determination. Chin. J. Pediatr. Emerg. Med. 2020, 3, 166–170. [Google Scholar]
- Cuevas, E.; Díaz, M.; Manzanares, M.; Zaldivar, D.; Perez-Cisneros, M. An improved computer vision method for white blood cells detection. Comput. Math. Methods Med. 2013, 2013, 137392. [Google Scholar] [CrossRef]
- Kasim, O.; Kuzucuoglu, A.E. Detection and classification of leukocyte cells from smear image. J. Fac. Eng. Archit. Gazi Univ. 2015, 30, 95–109. [Google Scholar]
- Cheng, K. Fuzzy Morphology Technology and Its Application in Image Processing; Nanjing University of Science and Technology: Nanjing, China, 2006. [Google Scholar]
- Lin, L.; Wang, W.; Chen, B. Leukocyte recognition with convolutional neural network. J. Algorithms Comput. Technol. 2018, 13, 1748301818813322. [Google Scholar] [CrossRef]
- Wang, X. Research on White Blood Cell Classification Algorithm Based on Deep Learning. Master’s Thesis, Huazhong Agricultural University, Wuhan, Hubei, 2023. [Google Scholar]
- Siddique, M.A.I.; Aziz, A.Z.B.; Matin, A. An improved deep learning based classification of human white blood cell images. In Proceedings of the 2020 11th International Conference on Electrical and Computer Engineering (ICECE), Dhaka, Bangladesh, 17–19 December 2020; pp. 149–152. [Google Scholar] [CrossRef]
- Gan, F.; Jiang, G.; Li, Z.; Chen, K. Peripheral blood white blood cell detection based on YOLOv5. Comput. Sci. Appl. 2022, 12, 1482–1488. [Google Scholar]
- Chen, Y.; Chen, Z.; An, Y.; Lu, C.; Qiao, X. DAFFNet: A Dual Attention Feature Fusion Network for Classification of White Blood Cells. arXiv 2024, arXiv:2405.16220. [Google Scholar] [CrossRef]
- Khan, R.; Mir, J. White blood cells segmentation and classification using U-Net CNN and hand-crafted features. In Proceedings of the 2022 International Conference on IT and Industrial Technologies (ICIT), Chiniot, Pakistan, 3–4 October 2022; pp. 1–7. [Google Scholar] [CrossRef]
- Dosovitskiy, A.; Beyer, L.; Kolesnikov, A.; Weissenborn, D.; Zhai, X.; Unterthiner, T.; Dehghani, M.; Minderer, M.; Heigold, G.; Gelly, S.; et al. An Image is Worth 16 × 16 Words: Transformers for Image Recognition at Scale. arXiv 2020, arXiv:2010.11929. [Google Scholar]
- Hou, Q.; Lu, C.Z.; Cheng, M.M.; Feng, J.S. Conv2Former: A simple transformer-style ConvNet for visual recognition. arXiv 2022, arXiv:2211.11943. [Google Scholar] [CrossRef] [PubMed]
- Wang, J.; Chen, K.; Xu, R.; Liu, Z.; Loy, C.C.; Lin, D. CARAFE: Content-Aware Reassembly of Features. In Proceedings of the IEEE/CVF International Conference on Computer Vision, Seoul, Republic of Korea, 27 October–2 November 2019; pp. 3007–3016. [Google Scholar]
- Bodla, N.; Singh, B.; Chellappa, R.; Davis, L.S. Soft-NMS—Improving object detection with one line of code. In Proceedings of the IEEE International Conference on Computer Vision (ICCV), Venice, Italy, 22–29 October 2017; pp. 5561–5569. [Google Scholar]

| White Blood Cell Subtype | (410) × 109/L Normal Reference Range | Pathologic Features Accompanying Concentration Bias | |
|---|---|---|---|
| Elevated | Decreased | ||
| Neutrophils (NEU) | 50–70% | Severe tissue injury, hemorrhage, acute suppurative infections, encephalitis B, etc. | Influenza, infectious diseases, measles, etc. |
| Eosinophils (EOS) | 0.5–5% | Allergic diseases, hematologic diseases, parasitic diseases, etc. | Taking hormonal drugs, myelodysplastic syndromes, typhoid fever, etc. |
| Basophils (BAS) | 0.5–1% | Rheumatoid arthritis, diabetes mellitus, malignancy, myelofibrosis, etc. | Hyperthyroidism, Cushing’s syndrome, aplastic anemia, etc. |
| Lymphocytes (LYM) | 20–40% | Pertussis, chronic lymphocytic leukemia, and viral infections; | Immunodeficiency, X-ray exposure, etc. |
| Monocytes (MON) | 3–8% | Malaria, tuberculosis, etc. | - |
| White Blood Cell Categories | Cytoplasmic Diameter | Proportion | Nucleus | Cytoplasm |
|---|---|---|---|---|
![]() neutrophil | 10–15 uL | About 50% to 70% of the total number of white blood cells | The nuclei are bluish-purple, rod-shaped, S-shaped, leaf-shaped, etc. | The cytoplasm is rich and full of neutral granules, which are fine and light blue in color. |
![]() lymphocyte | 6–15 uL | Accounts for approximately 20–40% of the total white blood cell count. | The nucleus is roughly round or oval and positioned to one side. | The cytoplasm is sparse or minimal, with purplish-red granules. |
![]() eosinophil | 11–16 uL | Approximately 0.5% to 5% of the total white blood cell count. | The nucleus is lobulated or rod-shaped, with clumped chromatin and distinct parachromatin. | The cytoplasm is abundant, round or oval, and evenly distributed. |
![]() monocyte | 12–20 uL | Accounts for approximately 3% to 8% of the total white blood cell count. | The nucleus is irregular and oval-shaped, with loose chromatin and no visible nucleolus. | The cytoplasm is abundant, light gray-blue, and slightly tinged with purplish-red. |
| Input: initial set of detection frames , set of detection scores }; Output: filtered set of test boxes ; | |
| While: | |
| // highest confidence detection frame | |
| Delete from B | |
| Add to K | |
| Calculate the penalization factor | |
| Confidence scores are updated | |
| Delete bi in B when less than the threshold σ | |
| return | 0.5 |
| Name | Parameter Description |
|---|---|
| Operating system | Windows10 |
| CPU | AMD EPYC 7542 |
| GPU | 3090-24 G |
| Memory | 127 G |
| CUDA version | 11.7 |
| Python | 3.8 |
| Pytorch | 1.13.1 |
| Name | Numerical Value |
|---|---|
| Image size | 640 × 640 × 3 |
| Batch size | 4 |
| lr0 | 0.01 |
| lrf | 0.1 |
| Optimizer | SGD |
| Weight decay | 0.0005 |
| Momentum | 0.937 |
| Core Network | Quantity of Participants/M | Computational Volume/G | MAP/% (NEU) | MAP/% (LYM) | MAP/% (MON) | MAP/% (EOS) | MAP/% (ALL) |
|---|---|---|---|---|---|---|---|
| ELAN | 36.5 | 103.9 | 95.1 | 91.0 | 78.0 | 66.5 | 82.6 |
| QARepVGG | 37.5 | 104.7 | 96.9 | 89.1 | 80.9 | 71.8 | 84.7 |
| ConvNext | 34.2 | 96.7 | 93.0 | 90.7 | 80.3 | 72.2 | 84.1 |
| Swin Transformer | 34.3 | 118.6 | 96.7 | 88.6 | 82.9 | 71.4 | 84.9 |
| RepGhost | 34.0 | 96.2 | 95.7 | 91.0 | 71.8 | 59.7 | 79.6 |
| EffQAFPN | 34.2 | 97.0 | 93.5 | 89.0 | 73.3 | 68.2 | 81.0 |
| GhostV2 | 33.9 | 96.0 | 94.5 | 89.0 | 75.0 | 63.3 | 80.5 |
| Conv2Former | 34.4 | 97.4 | 94.0 | 89.9 | 83.7 | 72.6 | 85.1 |
| Quantity of Participants/M | Computational Volume/G | MAP/% (NEU) | MAP/% (LYM) | MAP/% (MON) | MAP/% (EOS) | MAP/% (ALL) | ||
|---|---|---|---|---|---|---|---|---|
| 1 | 3 | 34.4 | 97.6 | 95.4 | 86.1 | 87.8 | 76.0 | 86.3 |
| 1 | 5 | 34.4 | 97.6 | 93.0 | 93.0 | 86.8 | 72.0 | 86.2 |
| 3 | 3 | 34.4 | 97.6 | 96.5 | 89.2 | 85.6 | 71.4 | 85.7 |
| 3 | 5 | 34.4 | 97.6 | 95.7 | 91.7 | 83.7 | 75.6 | 86.7 |
| 3 | 7 | 34.5 | 97.8 | 96.5 | 89.3 | 85.2 | 75.5 | 86.6 |
| 5 | 5 | 34.6 | 98.0 | 96.0 | 87.6 | 86.7 | 75.1 | 86.4 |
| 5 | 7 | 34.7 | 98.5 | 96.6 | 88.2 | 82.0 | 82.4 | 87.3 |
| Yolov7 | Data Enhancement Strategy | Conv2Former | CARAFE | EMA | Soft-NMS | Quantity of Participants/M | Computational Volume/G | MAP/% (ALL) |
|---|---|---|---|---|---|---|---|---|
| √ | 36.5 | 103.9 | 81.5 | |||||
| √ | √ | 36.5 | 103.9 | 82.6 | ||||
| √ | √ | 34.4 | 97.4 | 83.8 | ||||
| √ | √ | 36.5 | 104.1 | 84.1 | ||||
| √ | √ | 36.5 | 104.5 | 84.6 | ||||
| √ | √ | 36.5 | 103.9 | 81.8 | ||||
| √ | √ | √ | 34.4 | 97.4 | 85.1 | |||
| √ | √ | √ | √ | 34.4 | 97.6 | 86.7 | ||
| √ | √ | √ | √ | √ | 34.5 | 98.2 | 88.9 | |
| √ | √ | √ | √ | √ | √ | 34.5 | 98.2 | 89.3 |
| Core Network | Quantity of Participants/M | Computational Volume/G | MAP/% (NEU) | MAP/% (LYM) | MAP/% (MON) | MAP/% (EOS) | MAP/% (ALL) |
|---|---|---|---|---|---|---|---|
| SSD | 24.0 | 274.5 | 79.4 | 78.5 | 55.9 | 53.3 | 66.8 |
| Faster-RCNN | 136.8 | 401.8 | 82.6 | 79.0 | 72.5 | 54.6 | 72.1 |
| YOLOv4 | 52.4 | 119.7 | 93.2 | 87.4 | 75.2 | 54.7 | 77.6 |
| YOLOv5l | 46.5 | 109.1 | 92.5 | 87.4 | 82.4 | 65.3 | 81.9 |
| YOLOv5s | 7.1 | 16.5 | 94.5 | 89.0 | 75.0 | 63.3 | 80.5 |
| YOLOX | 54.2 | 155.6 | 95.1 | 91.0 | 78.0 | 66.5 | 82.6 |
| YOLOv6 | 34.9 | 85.8 | 93.5 | 89.0 | 73.3 | 68.2 | 81.0 |
| YOLOv7 | 36.5 | 103.9 | 93.2 | 89.6 | 78.5 | 64.7 | 81.5 |
| YOLOv8 | 36.2 | 105.6 | 95.4 | 90.1 | 80.1 | 74.5 | 87.3 |
| YOLOv11 | 35.8 | 96.7 | 94.1 | 89.2 | 87.6 | 71.8 | 84.7 |
| CCE-YOLOv7 | 34.5 | 98.2 | 96.4 | 90.4 | 90.4 | 79.9 | 89.3 |
Disclaimer/Publisher’s Note: The statements, opinions and data contained in all publications are solely those of the individual author(s) and contributor(s) and not of MDPI and/or the editor(s). MDPI and/or the editor(s) disclaim responsibility for any injury to people or property resulting from any ideas, methods, instructions or products referred to in the content. |
© 2025 by the authors. Licensee MDPI, Basel, Switzerland. This article is an open access article distributed under the terms and conditions of the Creative Commons Attribution (CC BY) license (https://creativecommons.org/licenses/by/4.0/).
Share and Cite
Li, M.; Wang, J.; Fang, S.; Yang, L.; Liu, X.; Yun, H.; Wang, X.; Du, Q.; Han, Z. Research and Optimization of White Blood Cell Classification Methods Based on Deep Learning and Fourier Ptychographic Microscopy. Sensors 2025, 25, 2699. https://doi.org/10.3390/s25092699
Li M, Wang J, Fang S, Yang L, Liu X, Yun H, Wang X, Du Q, Han Z. Research and Optimization of White Blood Cell Classification Methods Based on Deep Learning and Fourier Ptychographic Microscopy. Sensors. 2025; 25(9):2699. https://doi.org/10.3390/s25092699
Chicago/Turabian StyleLi, Mingjing, Junshuai Wang, Shu Fang, Le Yang, Xinyang Liu, Haijiao Yun, Xiaoli Wang, Qingyu Du, and Ziqing Han. 2025. "Research and Optimization of White Blood Cell Classification Methods Based on Deep Learning and Fourier Ptychographic Microscopy" Sensors 25, no. 9: 2699. https://doi.org/10.3390/s25092699
APA StyleLi, M., Wang, J., Fang, S., Yang, L., Liu, X., Yun, H., Wang, X., Du, Q., & Han, Z. (2025). Research and Optimization of White Blood Cell Classification Methods Based on Deep Learning and Fourier Ptychographic Microscopy. Sensors, 25(9), 2699. https://doi.org/10.3390/s25092699